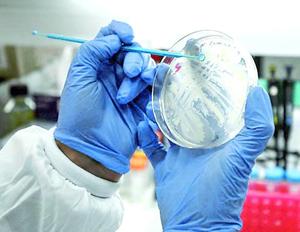

Más leídas

Actualidad | Pág. 2
Embarazada de 21 años es el primer caso de Covid en Curaco

Actualidad | Pág. 5
Hallan cuerpo en Quellón: frío sería causal del deceso

Actualidad | Pág. 5
Detienen a mujer que quebrantó cuarentena oculta en portamaletas

Actualidad | Pág. 5
Incautan más de 1.800 kilos de mariscos

Actualidad | Pág. 6
Corte ratifica cárcel para imputado por femicidio

Actualidad | Pág. 6
Joven va a prisión por tres delitos contra su padre

Actualidad | Pág. 6
relevo de marinos

Actualidad | Pág. 7
Quellón llora la partida de querido locutor radial

Actualidad | Pág. 3
Concejo prohíbe comercio callejero de no residentes

Actualidad | Pág. 3
CORE destina recursos a las barreras sanitarias

Actualidad | Pág. 3
Retoman entrega de cajas de alimentos en Chiloé

Actualidad | Pág. 8
Dirigentes del San Carlos valoran suspensión de obra

Actualidad | Pág. 8
Tribunal Ambiental rechazó reclamación contra la SMA por vertedero en la Isla

Estrellas | Pág. 19
Deepak Chopra lanza meditación bilingüe con J Balvin

Estrellas | Pág. 19
Así se hará el festival online de comedia con 85 humoristas

Estrellas | Pág. 19
"Está feliz, qué más quiero yo en la vida que eso"
Estrellas | Pág. 19
El Festival de Toronto planea alfombras rojas virtuales

Actualidad | Pág. 4
denuncia y ayuda
Actualidad | Pág. 4
humor

Actualidad | Pág. 11
Así será el regreso a clases de los primeros colegios en Chile

Actualidad | Pág. 11
Alhué e Isla de Maipo critican exclusión en la megacuarentena

Servicios | Pág. 13
Expertos dan tips para evitar daños en la piel por usar protección facial

Servicios | Pág. 13
Amazon anunció aumento en su huella de carbono

Servicios | Pág. 13
Erupción en Alaska provocó un duro enfriamiento en la Antigua Roma en el años 43 antes de Cristo
Servicios | Pág. 13
Médico estadounidense asegura que habrá a fin de año una vacuna contra el coronavirus

Deportes | Pág. 12
Eibar, con Fabián Orellana titular todo el duelo, venció a Valencia y se aleja del descenso

Deportes | Pág. 12
Benjamín Kuscevic reconoce sondeos desde Brasil para dejar la Universidad Católica

Deportes | Pág. 12
Polémica global: hasta Mister Chip defendió el récord de Paredes

Deportes | Pág. 12
Triunfo de Chelsea ante el City le da el título al Liverpool

Servicios | Pág. 14
cara: exfoliar con miel, limón y almendras

Servicios | Pág. 14
miel para mejorar y evitar labios partidos

Servicios | Pág. 14
sal gruesa y agua para exfoliar el cuerpo

Servicios | Pág. 14
agua de arroz para evitar la caída del pelo
Servicios | Pág. 14
Profesionales explican por qué ciertos ingredientes sirven para la belleza

Servicios | Pág. 14
aceites para hacer crecer las pestañas

Servicios | Pág. 14
yogur para tener un cabello más brillante

Servicios | Pág. 14
clara de huevo contra los puntos negros

Actualidad | Pág. 10
Covid bajó expansión en la RM: Minsal pide calma y alerta por otras alzas
Actualidad | Pág. 10
casos activos en comunas con cuarentena vigente

Servicios | Pág. 14
leche fría para eliminar molestas ojeras

Estrellas | Pág. 18
Francisco Pérez-Bannen cuenta cómo fue entrar a un río por rito mapuche